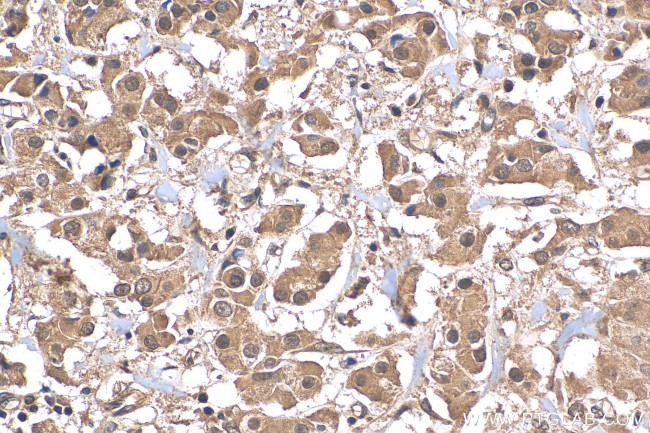
ATF4 Antibody in Immunohistochemistry (Paraffin) (IHC (P))

Search
Proteintech
ATF4 Recombinant Rabbit Monoclonal Antibody (5N3)
{{$productOrderCtrl.translations['antibody.pdp.commerceCard.promotion.promotions']}}
{{$productOrderCtrl.translations['antibody.pdp.commerceCard.promotion.viewpromo']}}
{{$productOrderCtrl.translations['antibody.pdp.commerceCard.promotion.promocode']}}: {{promo.promoCode}} {{promo.promoTitle}} {{promo.promoDescription}}. {{$productOrderCtrl.translations['antibody.pdp.commerceCard.promotion.learnmore']}}
产品信息
81798-1-RR
种属反应
宿主/亚型
Expression System
分类
类型
克隆号
抗原
偶联物
形式
纯化类型
保存液
内含物
保存条件
运输条件
产品详细信息
Immunogen sequence: MTEMSFLSSE VLVGDLMSPF DQSGLGAEES LGLLDDYLEV AKHFKPHGFS SDKAKAGSSE WLAVDGLVSP SNNSKEDAFS GTDWMLEKMD LKEFDLDALL GIDDLETMPD DLLTTLDDTC DLFAPLVQET NKQPPQTVNP IGHLPESLTK PDQVAPFTFL QPLPLSPGVL SSTPDHSFSL ELGSEVDITE GDRKPDYTAY VAMIPQCIKE EDTPSDNDSG ICMSPESYLG SPQHSPSTRG SPNRSLPSPG VLCGSARPKP YDPPGEKMVA AKVKGEKLDK KLKKMEQNKT AATRYRQKKR AEQEALTGEC KELEKKNEAL KERADSLAKE IQYLKDLIEE VRKARGKKRV P
靶标信息
This gene encodes a transcription factor that was originally identified as a widely expressed mammalian DNA binding protein that could bind a tax-responsive enhancer element in the LTR of HTLV-1. The encoded protein was also isolated and characterized as the cAMP-response element binding protein 2 (CREB-2). The protein encoded by this gene belongs to a family of DNA-binding proteins that includes the AP-1 family of transcription factors, cAMP-response element binding proteins (CREBs) and CREB-like proteins. These transcription factors share a leucine zipper region that is involved in protein-protein interactions, located C-terminal to a stretch of basic amino acids that functions as a DNA binding domain. Two alternative transcripts encoding the same protein have been described. Two pseudogenes are located on the X chromsome at q28 in a region containing a large inverted duplication.
仅用于科研。不用于诊断过程。未经明确授权不得转售。
篇参考文献 (0)
生物信息学
蛋白别名: Activating transcription factor 4; ATF 4; ATF4 protein; cAMP response element-binding protein 2; cAMP-dependent transcription factor ATF-4; cAMP-responsive element-binding protein 2; CREB 2; CREB-2; Cyclic AMP-dependent transcription factor ATF-4; Cyclic AMP-responsive element-binding protein 2; DNA-binding protein TAXREB67; OTTHUMP00000199130; tax-re; tax-responsive enhancer element B67; Tax-responsive enhancer element-binding protein 67; TaxREB67
基因别名: ATF4; CREB-2; CREB2; TAXREB67; TXREB
UniProt ID: (Human) P18848
Entrez Gene ID: (Human) 468